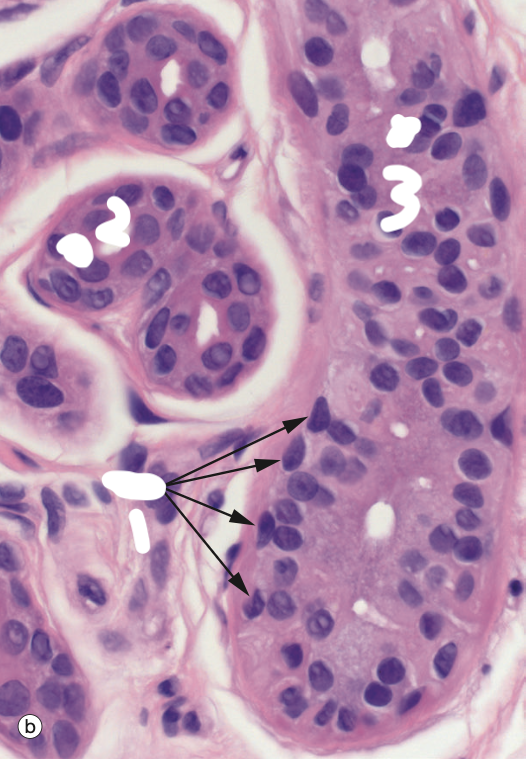
<p>Identify the Structure</p>

1/40
Looks like no tags are added yet.
Name | Mastery | Learn | Test | Matching | Spaced | Call with Kai |
|---|
No analytics yet
Send a link to your students to track their progress

Identify the Structure
Pilosebaceous unit; hair follicle, sebaceous (oil) gland, and arrector pili muscle
Function of Hair Follicle?
protection, thermoregulation, sensory
What is Hair Shaft made of?
Cuticle, Cortex, Medulla

Identify the Structure
Pilosebaceous unit; hair follicle, sebaceous (oil) gland, and arrector pili muscle

Identify the Structure
Hair Bulb; cone is Hair papillae and purple surr is Matrix

Identify the Structure
Hair Bulb; top beige = Co, simple squamous epit = Cu, above that = IRS, outer purple = ERS, hyaline cartilage = GM

Identify the Structure
Hair Shaft; middle = Co, simple squamous epit = Cu, dark purple and pink layer = IRS, epit/eye looking cells = ERS, hyaline cartilage = GM

Identify the Structure
Hair Shaft
1 = Medulla
2 = Cortex
3 = ERS
4 = IRS

Identify the Structure
Hair Shaft
1 = Medulla
2 = Cuticle
3 = Cortex
4 = ERS
5 = IRS?

Identify the Structure
Hair Shaft
1 = ^
2 = IRS

Identify the Structure
Hair Shaft
1 = IRS
2 = ERS
3 = Hair shaft/Medulla?
4 = GM
Function of Nails?
protection and tool

Identify the Structure
Nail
1 = Eponychium
2 = Hypochonium
3 = Hypochonium
4 = Nail root
Functions of Sebaceous Gland?
empties sebum into hair foll using Holocrine sec (deg itself)

Identify the Structure in the middle
Sebaceous Gland

Identify the Structure on the L and R
Sebaceous Gland

Identify the Structure
Sebaceous Gland
Function of Eccrine Sweat Gland?
cooling watery sec using Merocrine Sec (exocytosis); Glands = simple cuboidal epit, myoepit, lighter and Ducts = strat cuboidal epit, darker

Identify the Structure
Eccrine Sweat Gland (lighter, simple)
Ducts (darker, strat)

Identify the Structure
Eccrine Sweat Gland (lighter, simple)
Ducts (darker, strat)
Function of Apocrine Sweat Gland?
sec into hair foll using Merocrine Sec (exocytosis); Glands = pale/lighter, large irreg lumen and Ducts = smaller lumen, darker

Identify the Structure
Apocrine Sweat Gland

Identify the Structure
Apocrine Sweat Gland

Identify the Structure
Apocrine Sweat Gland
Meissner’s Corpuscle Function?
sensitivity to light touch in Dermal papillae
Pacinian Corpuscle Function?
sensitivity to vibration and P in deep dermis
Merkel Cell Function?
tactile receptors, endings synapse onto specialised cells in basale of epidermis

Identify the Structure
Meissner’s Corpuscle

Identify the Structure
Pacinian Corpuscle

Identify the Structure
Pacinian Corpuscle

Identify the Structure
Merkel Cells
Functions of Integu Sys?
Circularion/regulation and Temp regu and nutrients

Identify the Structure
1 = Papillary loops
2 = Subpapillary plexus
3 = Cutaneous plexus

Identify the Structure
1 = Sebaceous gland
2 = Arrector pili M
3 = Hair foll
4 = Sebaceous gland

Identify the Structure
Sebaceous Gland

Identify the Structure
Top = Eccrine sweat gland
Bottom = Eccrine sweat duct
Identify the Structure
1 = Myoepithelial cells
2 = Eccrine sweat duct
3 = Eccrine sweat gland

Identify the Structure
Apocrine SwG

Identify the Structure
Apocrine SwG
1 and 3 = myoepithelial cells

Identify the Structure
1 = Hair foll
2 and 3 = Apocrine SwG

Identify the Structure
Sebaceous Glands